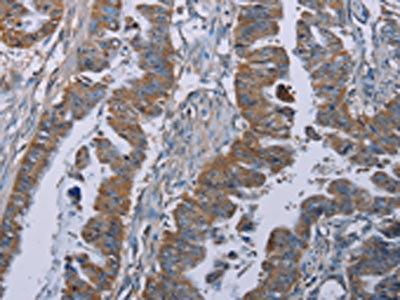

BMP3 Antibody
-
中文名稱:BMP3兔多克隆抗體
-
貨號:CSB-PA192641
-
規格:¥1100
-
圖片:
-
其他:
產品詳情
-
Uniprot No.:
-
基因名:BMP3
-
別名:BMP-3 antibody; BMP-3A antibody; bmp3 antibody; BMP3_HUMAN antibody; BMP3A antibody; Bone morphogenetic protein 3 (osteogenic) antibody; Bone morphogenetic protein 3 antibody; Bone morphogenetic protein 3A antibody; Osteogenin antibody
-
宿主:Rabbit
-
反應種屬:Human
-
免疫原:Synthetic peptide of Human BMP3
-
免疫原種屬:Homo sapiens (Human)
-
標記方式:Non-conjugated
-
抗體亞型:IgG
-
純化方式:Antigen affinity purification
-
濃度:It differs from different batches. Please contact us to confirm it.
-
保存緩沖液:-20°C, pH7.4 PBS, 0.05% NaN3, 40% Glycerol
-
產品提供形式:Liquid
-
應用范圍:ELISA,IHC
-
推薦稀釋比:
Application Recommended Dilution ELISA 1:1000-1:2000 IHC 1:25-1:100 -
Protocols:
-
儲存條件:Upon receipt, store at -20°C or -80°C. Avoid repeated freeze.
-
貨期:Basically, we can dispatch the products out in 1-3 working days after receiving your orders. Delivery time maybe differs from different purchasing way or location, please kindly consult your local distributors for specific delivery time.
-
用途:For Research Use Only. Not for use in diagnostic or therapeutic procedures.
相關產品
靶點詳情
-
功能:Growth factor of the TGF-beta superfamily that plays an essential role in developmental process by inducing and patterning early skeletal formation and by negatively regulating bone density. Antagonizes the ability of certain osteogenic BMPs to induce osteoprogenitor differentitation and ossification. Initiates signaling cascades by associating with type II receptor ACVR2B to activate SMAD2-dependent and SMAD-independent signaling cascades including TAK1 and JNK pathways.
-
基因功能參考文獻:
- This study demonstrated that there was a significantly higher frequency of BMP3 methylated DNA in plasma in patients with polyps versus healthy controls with a sensitivity and specificity of 40 and 94%, respectively. PMID: 29892846
- BMP3 - the biomarker of a currently in-use multi-target stool DNA test was commonly expressed in tumor tissue specimens, independent of Fecal Immunochemical Test result. PMID: 28044229
- Methylation level in stool decreases dramatically following colorectal cancer resection PMID: 24993691
- Bone morphogenic protein 3 signaling in the regulation of osteogenesis. PMID: 23127436
- As an addition to PRKG2 and RASGEFIB genes, we propose to include BMP3 gene as the principal determinant of the observed common phenotype. PMID: 22303795
- a critical link between HNF1A-MODY-induced alterations in Bmp-3 expression and insulin gene levels PMID: 21628466
- Features supportive of positive selection in the BMP3 gene were found including the presence of an excess of nonsynonymous mutations in modern humans, and a significantly lower genetic diversity that deviates from neutrality PMID: 20532035
- Data suggest that promotor region methylation of the BMP3 gene may cause gastric carcinoma in Chinese people. PMID: 20238409
- These results demonstrate that BMP-3 stimulates mesenchymal stem cell proliferation via the TGF-beta/activin signaling pathway. PMID: 20143330
- The expression signals of BMP3 mRNA in malignant schwannoma were relatively lower than in benign lesions PMID: 11642720
- BMP-3 receptor specificity is controlled by the interaction of Lys-30 of BMP-3 with Glu-76 of ActRIIb PMID: 17924656
- BMP3 silencing is an early and frequent event in colorectal tumors progressing via the serrated and traditional pathways. PMID: 18311777
顯示更多
收起更多
-
亞細胞定位:Secreted.
-
蛋白家族:TGF-beta family
-
組織特異性:Expressed in adult and fetal cartilage.
-
數據庫鏈接:
Most popular with customers
-
-
Phospho-YAP1 (S127) Recombinant Monoclonal Antibody
Applications: ELISA, WB, IHC
Species Reactivity: Human
-
-
-
-
-
-